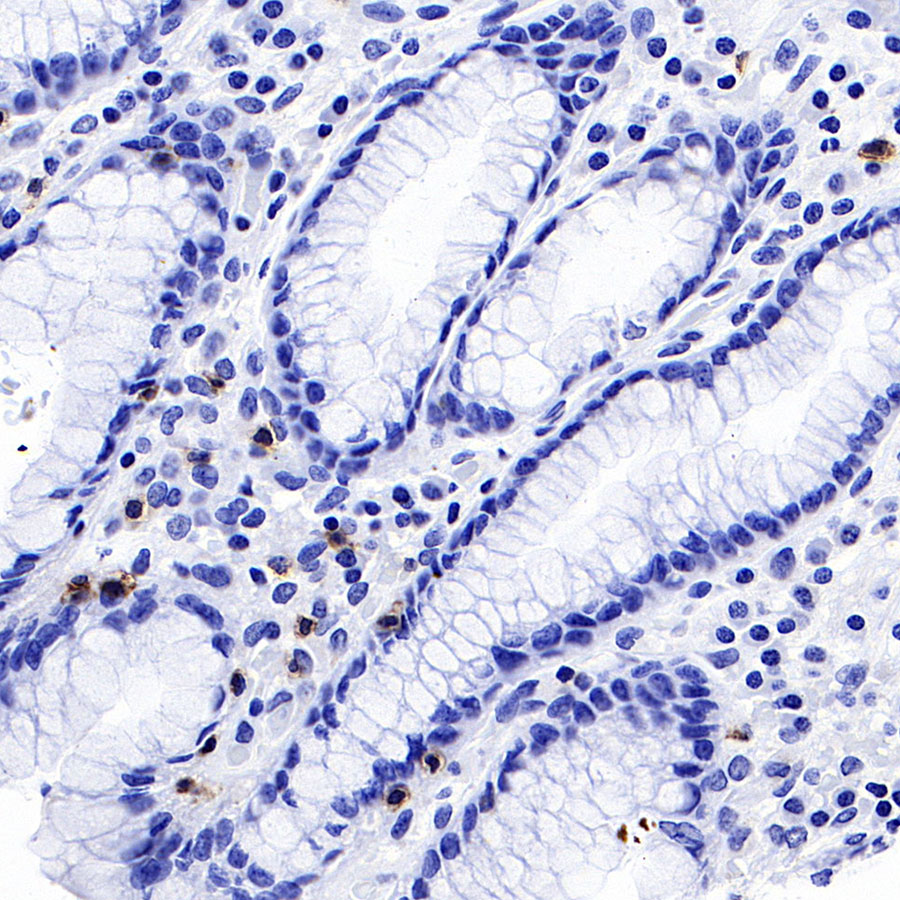

IHC shows positive staining in paraffin-embedded human stomach. Anti-CD8α antibody was used at 1/1000 dilution, followed by a HRP Polymer for Mouse & Rabbit IgG (ready to use). Counterstained with hematoxylin. Heat mediated antigen retrieval with Tris/EDTA buffer pH9.0 was performed before commencing with IHC staining protocol.
Product Details
Product Details
Product Specification
| Host | Mouse |
| Antigen | CD8α |
| Synonyms | T-lymphocyte differentiation antigen T8/Leu-2, T-cell surface glycoprotein CD8 alpha chain, MAL, CD8a |
| Immunogen | Synthetic Peptide |
| Location | Cell membrane |
| Accession | P01732 |
| Clone Number | SDT-126-8 |
| Antibody Type | Mouse mAb |
| Isotype | IgG1,k |
| Application | IHC-P |
| Reactivity | Hu |
| Purification | Protein G |
| Concentration | 2 mg/ml |
| Physical Appearance | Liquid |
| Storage Buffer | PBS, 40% Glycerol, 0.05% BSA, 0.03% Proclin 300 |
| Stability & Storage | 12 months from date of receipt / reconstitution, -20 °C as supplied |
Dilution
| application | dilution | species |
| IHC-P | 1:2000 |
Background
CD8A encodes the CD8 alpha chain of the αβT cells, proposed as a quantifiable indicator for CD8+ CTL recruitment or activity assessments and a robust biomarker for responses to anti-PD-1/PD-L1 therapy.In NK-cells, the presence of CD8A homodimers at the cell surface provides a survival mechanism allowing conjugation and lysis of multiple target cells. CD8A homodimer molecules also promote the survival and differentiation of activated lymphocytes into memory CD8 T-cells.
Picture
Picture
Immunohistochemistry

IHC shows positive staining in paraffin-embedded human tonsil. Anti-CD8α antibody was used at 1/1000 dilution, followed by a HRP Polymer for Mouse & Rabbit IgG (ready to use). Counterstained with hematoxylin. Heat mediated antigen retrieval with Tris/EDTA buffer pH9.0 was performed before commencing with IHC staining protocol.

IHC shows positive staining in paraffin-embedded human tonsil. Anti-CD8α antibody was used at 1/1000 dilution, followed by a HRP Polymer for Mouse & Rabbit IgG (ready to use). Counterstained with hematoxylin. Heat mediated antigen retrieval with Tris/EDTA buffer pH9.0 was performed before commencing with IHC staining protocol.
